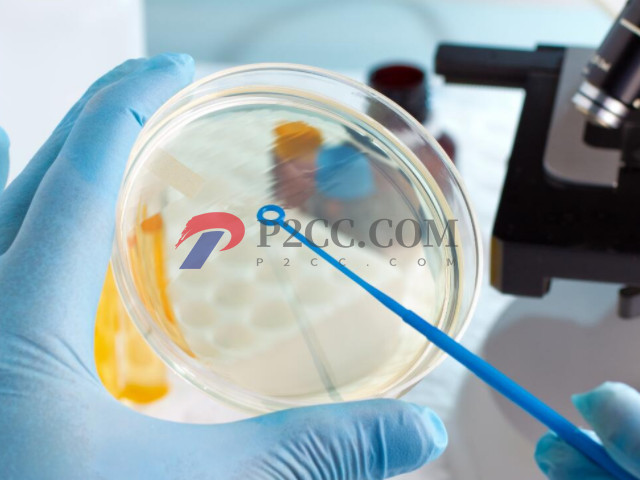

三代试管详细流程讲解,从前期检查到移植大概就2至3个月
三代试管婴儿技术现目前在国内是比较普遍的,像北医三院、中信湘雅、上海瑞金、山大生殖都是可以开展第三代试管婴儿技术的,而且平均试管成功率在40%以上,已经居于国际水平了。不过还是有很多人对于第三代试管婴儿的大致流程和所需要的时间是不了解的,从而无法规划好生活、工作、手术,所以今天就来和大家说说关于三代试管的大致流程和时间。

第三代试管婴儿流程
第三代试管婴儿又称为胚胎植入前遗传学检测,简称PGT,是指在胚胎移植前,对体外受精的胚胎进行遗传物质分析,排除携带已知致病基因的胚胎,将从基因层面优选后的胚胎移植入宫腔,不仅能够提高体外受精-胚胎移植技术的成功率,而且避免了流产,治疗性引产带给女性身体及精神上的创伤。下面是具体的流程:
- 1. 身体检查:在进行试管手术前期,夫妻双方需要到医院生殖中心进行一个全面的身体检查,检查项目比较多,一般女性需返院2-3次完成检查,一次为月经周期的第2-4天,一次为月经干净时。男方就1-2次就可以完成,检查完成后大概1-2个星期就会出结果,而整个过程需要1个月左右的样子;
- 2. 试管建档:在检查结果出来后就可以进行建档了,夫妻需要携带身份证、结婚证、生育证建档,并签署知情同意书。一般当天即可完成;
- 3. 制定促排卵方案一般在建档完成后,下次来月经的第2天需要返院进行促排卵方案的制定,生会根据患者的具体情况选择合适的方案,一般当天就可以完成;
- 4. 降调:在正式促排前期需要先进行降调,因为促排卵方案的不一样,降调的时间也是不一样的,为后续多个卵泡同时发育做准备。降调的时间因人而异,而且像拮抗剂、微刺激、PPOS方案则无降调节阶段,直接进入促排周期;
- 5. 促排卵:进入促排卵周期,需每天使用促排卵药物,可以是注射类,也可以能是口服类,从国促排卵可以促使卵泡生长,然后间隔2-4天上医院进行卵泡监测,整个过程时间也是看自身的促排卵方案,一般需要8-15天不等,返院次数4-8次不等,并且间隔时间将逐渐缩短,后期可能需要每日返院。等到卵泡成熟后就打夜针,然后在34-36小时后进去取卵;
- 6. 移植:在取卵当天也是需要取精,最后把精子和卵子送到实验室授精培养,胚胎3-5天进行移植,当然如果说无法鲜胚移植就需要考虑冻胚移植,这个时间不定。
上面就是做三代试管的大致流程和时间安排,一般在移植后的14天就可以回医院进行抽血验孕,如果确认怀孕需要进行保胎工作,如果没有怀孕需要先找到原因,然后进行调控,在准备二次移植手术。
第三代试管整个过程需多久
做第三代试管婴儿需要多久时间是因人而异的,具体要看促排方案和身体情况,如果一切顺利,整个过程大约需要2-3个月。一般来说,从公告到试管婴儿周期的开始和结束,你要去试管婴儿医院10次左右,如果不顺利的话,可能会延长的更久,比如说需要进行宫腔镜手术,或者其他会影响到移植成功的疾病,需要通过治疗后才能移植的。
但是这里说的几个月不是说这中间都是在试管周期中,而是身体自身情况或者个人意愿、试管环节中还没完成等情况,导致整个第三代试管婴儿周期延长。中间大部分时间可能在调理身体或治疗,等到有健康胚胎可以移植的时候才移植。所以,第三代试管婴儿每个人具体需要多久看的方案和实际情况。





